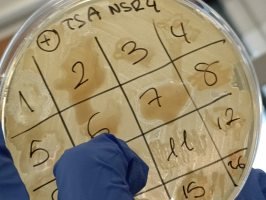

Colexio plurilingüe Nuestra Señora de los Remedios (Santiago)

- 11 de febreiro de 2026
PROXECTO MICROMUNDO 2026
Onte rematamos a nosa experiencia como microbiólogos e microbiólogas no proxecto MICROMUNDO.
Está claro que esto do COIDADO, o obxectivo xeral anual dos centros vicencianos, está estreitamente relacionado con isto de facer ciencia.
Tivemos que ser coidadosos, traballar con método, atinando e tendo boa conta do que faciamos. Foi por iso que acabamos atopando os halos de inhibición que nos fixeron caer na conta do potencial que poden ter os microorganismos do solo como posibles productores de antibióticos.
Pagaou a pena a experiencia, a valoración moi positiva por parte de todos.
Próxima parada: o acto de clausura, faremos posta en común do traballo de todos os participantes.
Un proxecto altamente recomendable!